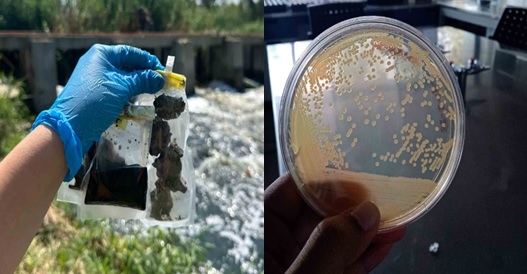

El Río Santiago, una de las venas acuáticas más importantes de Jalisco, enfrenta una compleja situación de contaminación. Lejos de ser un ecosistema inerte, en su interior bulle una vida microscópica que libra una batalla química constante por sobrevivir.
Por esto, científicos de la Universidad Autónoma de Guadalajara (UAG) se han dado a la tarea de descifrar este intrigante proceso natural.
El proyecto de investigación busca comprender un fascinante mecanismo de autorregulación que ya ocurre en el río: cómo ciertos microorganismos son capaces de producir sustancias que les permiten coexistir con contaminantes, entre los que se encuentran los metales pesados.
Estrategia de supervivencia microscópica
Frente a la presencia de metales, muchas bacterias activan un mecanismo de defensa: secretan unos compuestos conocidos como metalóforos. Imagina estas moléculas como imanes que atrapan a los metales por diferencias de cargas.
Este proceso, demostrado en numerosas investigaciones previas, es conocido como «quelación», el cual tiene un efecto crucial: inmoviliza los metales y reduce drásticamente su toxicidad, permitiendo que los microbios sobrevivan en un ambiente hostil, o que facilite la adquisición de micronutrientes.
Al hacerlo, estos diminutos habitantes están modificando la química de su entorno inmediato.
Detectives en el laboratorio
El equipo de la UAG, integrado por el Dr. Marco Antonio Zárate Navarro, la Dra. Nidia Nereyda García Valdez, la Dra. Fabiola Padilla Arizmendi, la Dra. Karina Sandoval García y los estudiantes de la Carrera de Ingeniería en Biotecnología, Mariana Rubí Corona Ramírez; Químico Fármaco Biólogo, Esthefanya Rangel Domínguez; e Ingeniería en Biotecnología, Sofía Jaime Vargas, investigan para comprender este proceso:
- Muestreo: Recolectaron muestras de agua y sedimentos del río Santiago, el escenario mismo de esta interacción.
- La Colección de Suspectos: En el laboratorio, aislaron y purificaron 192 cepas de microorganismos diferentes, obtenidas de las muestras del río.
- Identificando a los Productores: Comenzaron a probar estas cepas para descubrir cuáles de ellas son capaces de producir los «metabolitos de interés» ante la presencia de metales como hierro, zinc, cobalto, cobre y níquel.
- Los Primeros Indicios: De las cepas analizadas hasta ahora, alrededor de 7 han mostrado una capacidad notable, generando estos compuestos para varios metales. Son candidatos prometedores en este complejo entramado ecológico.
Compromiso compartido con el entorno
La relevancia de comprender estos mecanismos naturales ha despertado el interés de diversos actores. Ejemplo de ello es la colaboración con CITSIA, que, si bien opera en un sector distinto, manifiesta a través de este vínculo su compromiso y apoyo a la ciencia básica como pilar para un desarrollo más sostenible.
El valor de esta investigación no reside en una varita mágica de descontaminación, sino en la adquisición de conocimiento fundamental. Entender qué cepas hacen esto, para qué metales y en qué cantidad es el primer paso indispensable para, en un futuro, explorar si estos procesos naturales pueden ser guiados o potenciados.
«Estamos cartografiando una capacidad autóctona del río», mencionó el equipo de esta investigación, «comprendemos que la solución a un problema tan complejo no es única, pero descifrar cómo la propia naturaleza intenta autorregularse nos da pistas valiosas y nos enseña lecciones de resiliencia».
Este proyecto es un recordatorio de que los ecosistemas, incluso los impactados, poseen una intrincada red de mecanismos de defensa. La ciencia, en este caso, no llega para «salvar el día», sino para escuchar, aprender y documentar el silencioso, pero constante, pulso de la vida.
El equipo también agradeció al COECytJAL a través del proyecto FODECIJAL-11178 por su apoyo.
Información. Comunicación UAG.